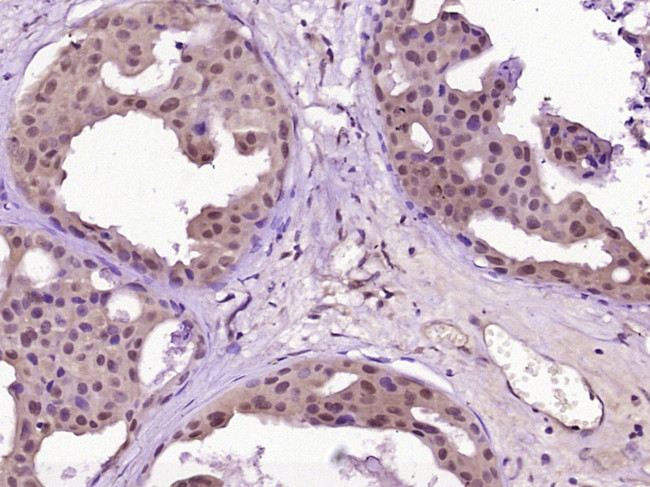
WEE1 Antibody in Immunohistochemistry (Paraffin) (IHC (P))

Search
Bioss
WEE1 Polyclonal Antibody
{{$productOrderCtrl.translations['antibody.pdp.commerceCard.promotion.promotions']}}
{{$productOrderCtrl.translations['antibody.pdp.commerceCard.promotion.viewpromo']}}
{{$productOrderCtrl.translations['antibody.pdp.commerceCard.promotion.promocode']}}: {{promo.promoCode}} {{promo.promoTitle}} {{promo.promoDescription}}. {{$productOrderCtrl.translations['antibody.pdp.commerceCard.promotion.learnmore']}}
图: 1 / 2
WEE1 Antibody (BS-23526R) in IHC (P)


产品信息
BS-23526R
种属反应
宿主/亚型
分类
类型
抗原
偶联物
形式
浓度
规格
纯化类型
保存液
内含物
保存条件
运输条件
靶标信息
WEE1, which is classified as a Ser/Thr kinase by sequence analysis, has been shown to inactivate multiple CDKs by tyrosine phosphorylation. Wee1 protein catalyzes the inhibitory tyrosine phosphorylation of CDC2/cyclin B kinase, and appears to coordinate the transition between DNA replication and mitosis by protecting the nucleus from cytoplasmically activated CDC2 kinase.
仅用于科研。不用于诊断过程。未经明确授权不得转售。
篇参考文献 (0)
生物信息学
蛋白别名: DKFZp686I18166; FLJ16446; protein kinase; unnamed protein product; wee 1 homolog; WEE1 homolog; Wee1 Hu; WEE1 tyrosine kinase; WEE1+ homolog; Wee1-like protein kinase; Wee1A kinase; WEE1hu
基因别名: WEE1; WEE1A; WEE1hu
UniProt ID: (Human) P30291, (Mouse) P47810, (Rat) Q63802
Entrez Gene ID: (Human) 7465, (Mouse) 22390, (Rat) 308937